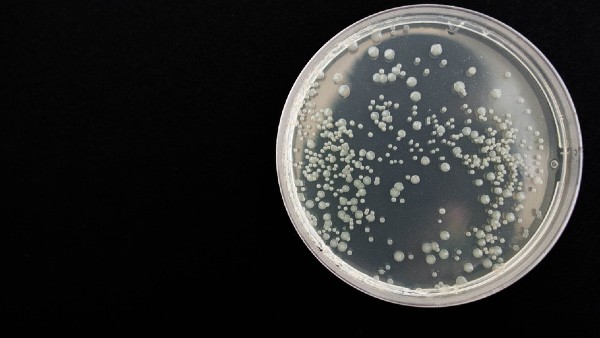
সবথেকে বড় ব্যাকটেরিয়াম ম্যাগনিফিকা সবথেকে বড় ব্যাকটেরিয়াম ম্যাগনিফিকা

৫০০০ গুণ বড়ো দৈত্যাকার ব্যাকটেরিয়াম আবিষ্কার, সন্ধান মিলেছে ম্যানগ্রোভ অরণ্যে
৫০০০ গুণ বড়ো দৈত্যাকার ব্যাকটেরিয়াম আবিষ্কার, সন্ধান মিলেছে ম্যানগ্রোভ অরণ্যে
স্বাভাবিক ব্যাকটেরিয়ার থেকে ৫০০০ গুণ বড়ো দৈত্যাকার ব্যাকটেরিয়ের সন্ধান পাওয়া গিয়েছে ম্যানগ্রোভ জলাভূমিতে। অন্যান্য পরিচিত দৈত্য ব্যাকটেরিয়া থেকেও এই ব্যাকটেরিয়া ৫০ গুণ বড়। ক্যারিবিয়ান ম্যানগ্রোভ জলাভূমিতে পাওয়া এই বিশাল ব্যাকটেরিয়া এখন পর্যন্ত পাওয়া সবথেকে বড়ো ব্যাকটেরিয়া।
সবথেকে বড় ব্যাকটেরিয়াম ম্যাগনিফিকা
বিজ্ঞানীরা এখন গবেষণায় বসেছে, কীভাবে ওই ব্যাকটেরিয়ামটি এত বিশাল আকারে বেড়ে গেল। তা খুঁজে বের করাই এখন তাঁদের লক্ষ্য হয়ে উঠেছে। এই ব্যাকটেরিয়ার নাম দেওয়া হয়েছে ম্যাগনিফিকা। এই ম্যাগনিফিকা নামটিও 'বড়ো' এবং ফরাসি শব্দ 'ম্যাগনিফিক' থেকে এসেছে তা। ল্যাটিন শব্দেরও উল্লেখ করে ওই নাম।

ম্যাগনিফিকা আবিষ্কার নিয়ে সামুদ্রিক জীববিজ্ঞানীর গবেষণা
ক্যালিফোর্নিয়া-ভিত্তিক সামুদ্রিক জীববিজ্ঞানী গবেষণার প্রধান লেখক জিন-মেরি ভোল্যান্ড বলেন, "এই ব্যাকটেরিয়া প্রসঙ্গে বলতে গেলে তা এতই বিশাল আকার নেবে যে, তা মাউন্ট এভারেস্টের মতো লম্বা একজন মানুষের মুখোমুখি হওয়ার মতো হবে।" ২০০৯ সালে গুয়াদেলুপের সবুজ দ্বীপগুলির একটিতে সেন্টিমিটার লম্বা টি-ম্যাগনিফিকা আবিষ্কৃত হয়েছিল। তারপর এটাও একটি ম্যাগনিফিকা আবিষ্কার হল।

পাতা ও ময়লার ওপরে ভেসেছিল ওই ব্যাকটেরিয়া
আবিষ্কারের সময় সামুদ্রিক জীববিজ্ঞানের অধ্যাপক অলিভিয়ার গ্রোস শক্তি উৎপন্ন করতে সালফার ব্যবহার করে ব্যাকটেরিয়া খুঁজছিলেন। যদিও তিনি একটি পেট্রি ডিশে জলাভূমির জলের নমুনা টিপ দেওয়ার পরে খুব অদ্ভুত কিছু লক্ষ্য করেছিলেন। খালি চোখে দৃশ্যমান পাতলা, 'ভার্মিসেলি'র মতো সুতোগুলো পাতা ও ময়লার ওপরে ভেসেছিল।

নিজের চোখে দেখার পর কী ভেবেছিলেন বিজ্ঞানী
তিনি বলেন, "আমি যখন ওইগুলি দেখেছিলাম, ভেবেছিলাম- এ তো বড়ো 'অদ্ভুত' ব্যাপার! শুরুতে আমি ভেবেছিলাম এটি কেবল কৌতূহলী কিছু, কিছু সাদা ফিলামেন্ট যা পাতার মতো পলির মধ্যে কিছুর সাথে সংযুক্ত করা রয়েছে। তারপর এক দশকেরও বেশি সময় ধরে বেশ কিছু গবেষক অদ্ভুত ছোট প্রোক্যারিওটগুলি পরীক্ষা করেছেন। মাইক্রোস্কোপগুলি পর্যবেক্ষণের পর এই ধারণায় উপনীত হওয়া গিয়েছে যে, ওটি দৈত্যাকার ব্যকটেরিয়াম।"

বিশাল ব্যাকটেরিয়া, যেভাবে নিশ্চিত হলেন বিজ্ঞানীরা
অস্বাভাবিক ওই জীবটিকে ফ্লুরোসেন্স, এক্স-রে, ইলেক্ট্রন মাইক্রোস্কোপি এবং জিনোম সিকোয়েন্সিং ব্যবহার করে ধাক্কা দেওয়া হয়েছে। তারপর বিজ্ঞানীরা নিশ্চিত হন যে এটি আসলে একটি বিশাল একক-কোষের ব্যাকটেরিয়া। সম্প্রতি এক সায়েন্স জার্নালে ও গবেষণার ফলাফলের প্রতিবেদন প্রকাশিত হয়েছে। গবেষক দলটি বেশ কয়েকটি কৌতূহলী প্রক্রিয়া প্রকাশ করেছে, যা ব্যাখ্যা করেছে- কীভাবে ব্যাকটেরিয়া আকারে অপরিসীম বেড়েছে।

ব্যাকটেরিয়াটি প্রোক্যারিওট নামক গোষ্ঠীর অন্তর্গত
বৃহত্তর, বহুকোষী জীবের বিপরীতে আমাদের মতো ইউক্যারিওট কোষে নিউক্লিয়াসের মতো ঝিল্লি আবদ্ধ অর্গানেল থাকে। তা ব্যাকটেরিয়া প্রোক্যারিওট নামক জীবের একটি গোষ্ঠীর অন্তর্গত। ঐতিহ্যগতভাবে সেগুলিকে 'এনজাইমের অসঙ্গতিপূর্ণ ব্যাগ' বলে মনে করা হয়, যার কোনো অভ্যন্তরীণ ঝিল্লি নেই। আদতে তা জিনগত উপাদান।

টি. ম্যাগনিফিকা ব্যাকটেরিয়া স্বাভাবিক ধারণার চ্যালেঞ্জ
টি-ম্যানিফিকা ডিএনএ এবং রাইবোসোম সঞ্চয় করার জন্য অভ্যন্তরীণ ঝিল্লির মধ্যে থাকে। গবেষকরা এই ক্ষুদ্র ব্যাকটেরিয়া অর্গানেলগুলিকে 'পেপিনস' (তরমুজ বা কিউইয়ের মতো ফলের ভিতরে পাওয়া ছোট বীজ) বলে উল্লেখ করেছেন। গবেষকরা জানান, "যেহেতু এটি ঝিল্লি-আবদ্ধ অর্গানেলগুলি থেকে এর জেনেটিক উপাদানগুলিকে আলাদা করে, সেহেতু ওই টি. ম্যাগনিফিকা ব্যাকটেরিয়া আমাদের ধারণাকে চ্যালেঞ্জ করে।"

টি-ম্যাগনিফিকার মধ্যে অভ্যন্তরীণ ঝিল্লি রয়েছে
যেহেতু টি-ম্যাগনিফিকার মধ্যে অভ্যন্তরীণ ঝিল্লি রয়েছে, এটি প্রোটিন মেশিনগুলিকে বিতরণ করতে পারে, যা কোষের শক্তির মুদ্রা এডিনোসিন ট্রাইফসফেট তৈরি করে। অন্যান্য ব্যাকটেরিয়াগুলির অভ্যন্তরীণ ঝিল্লি নেই। তাই এটিপি-উৎপাদনকারী মেশিন (এটিপি সিনথেস) রাখার একমাত্র জায়গা হল কোষের খামে, যা সমগ্র জীবকে আবদ্ধ করে রাখে।

বেশিরভাগ ব্যাকটেরিয়ার সীমাবদ্ধতা রয়েছে
গবেষকরা আরও জানান, যেহেতু এই শক্তিটি খুব দূরে পরিবহন করা কঠিন, এই সীমাবদ্ধতা বেশিরভাগ ব্যাকটেরিয়া কোষের আকারকে সীমিত করে রাখে। বেশিরভাগ ব্যাকটেরিয়ার আরেকটি সীমাবদ্ধতা হল তারা অবশ্যই আয়তনের দ্বিগুণ করতে সক্ষম হয়, যাতে তারা পুনরুৎপাদনের জন্য অর্ধেক ভাগ নিজেরে দখলে রাখতে পারে।

অন্যান্য ব্যাকটেরিয়ার তুলনায় অনেক বড় জিনোম
অন্যান্য ব্যাকটেরিয়া থেকে ভিন্ন টি-ম্যাগনিফিকা শুধুমাত্র একটি কন্যা কোষ তৈরি করতে সক্ষম। নিজের একটি ছোট অংশ বিচ্ছিন্ন করে এরা। তাই এই সীমাবদ্ধতা। টি-ম্যাগনিফিকাতে অন্যান্য ব্যাকটেরিয়ার তুলনায় অনেক বড় জিনোম রয়েছে। গড় প্রোক্যারিওটের জন্য ৩৯৩৫ জিনের তুলনায় ১১,৭৮৮ জিন।












Click it and Unblock the Notifications